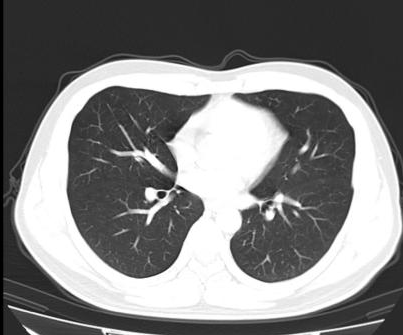

Clinical images
▶ Head, inner ear
 |  |  |
▶ Chest Automatic Milliampere-based technology, low-dose scanning image
 |  |  |
▶3D images
 |  |  |
▶MPR, VE images
 |  |
 | |

▶ Head, inner ear
 |  |  |
▶ Chest Automatic Milliampere-based technology, low-dose scanning image
 | |  |
▶3D images
 |  |  |
▶MPR, VE images
 |  |
 | |